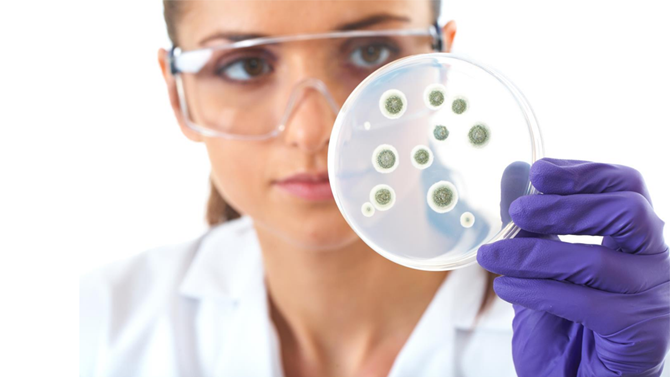

Assessment of Antibiotic Resistant Escherichia Coli in Meat Production Systems on the Island of Ireland
- Project start date: 1 June 2013
- Project status: Completed
- Project type: Food safety
- Discipline: Microbiology and food hygiene
- Author/s: Dr Robert Madden, Agri-Food and Biosciences Institute, Belfast
- Collaborator/s: Prof Martin Cormican & Dr Cyril Carroll, National University of Ireland, Galway
Research objective
The primary objective of this research was to assess the pathogenic potential of antibiotic-resistant Escherichia coli (AREC), particularly those producing Extended Spectrum β-Lactamase (ESBL), in foods derived from animal production systems on the island of Ireland (IOI). The study aimed to determine the prevalence of AREC in raw meat, define the phenotypic and genotypic properties of positive isolates, and evaluate the potential risks these organisms posed to consumers. Additionally, the research sought to understand the origins and dispersal mechanisms of AREC and propose prophylactic measures to limit consumer exposure to ESBL-producing bacteria.
Outputs
Research report
- Title: Assessment of antibiotic resistant Escherichia coli in meat production systems
- Publication date: 1 August 2016
- Summary: This study investigated the prevalence and characteristics of antibiotic-resistant Escherichia coli (AREC) in raw meat on the island of Ireland (IOI) to evaluate the risks posed to consumers. The focus was on E. coli strains resistant to three key classes of antimicrobials: fluoroquinolones, cephalosporins, and carbapenems.
- Findings:
1. Prevalence of AREC:
- From 600 samples, nearly 500 presumptive AREC isolates were obtained, with 485 confirmed as E. coli.
- Chicken had the highest prevalence of AREC (99%), followed by pork (32.5%) and beef (14%).
2. Resistance patterns:
- Out of 485 confirmed E. coli isolates, 143 were identified as ESBL producers (1 from beef, 130 from chicken, and 12 from pork).
- A significant number of isolates (326) showed resistance to at least one antimicrobial, with high resistance to ciprofloxacin and nalidixic acid, particularly in chicken.
3. Carbapenem resistance:
- No carbapenem resistance was detected in any E. coli isolates from this representative survey.
4. Comparison with human data:
- The majority of ESBL-producing E. coli in retail meat were not similar to those associated with human infections on the IOI, indicating limited direct contribution to human ESBL infections.
- Recommendations:
- Measures to control fluoroquinolone and cephalosporin-resistant E. coli should prioritise reducing antimicrobial use and managing human-to-human transmission rather than focusing solely on raw meat.
- The high prevalence of antimicrobial-resistant E. coli in chickens and pigs warrants further investigation to understand the underlying causes.
- The prevalence of AREC in retail meat likely reflected a high prevalence in the source animals, necessitates further study into the implications for animal health and veterinary practices.
You can download the report below.